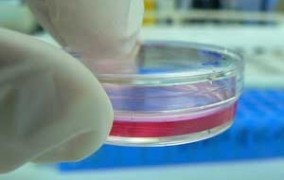

Notícias
-
Abertas as inscrições para curso sobre gestão cultural
19 de julho de 2017Cátedra Olavo Setúbal de Arte, Cultura e Ciências selecionará até 30 interessados; prazo de inscrição encerra em 23 de julho -
Vírus oropouche pode emergir e causar problemas de saúde pública no Brasil
19 de julho de 2017Vetor do vírus, antes restrito aos pequenos vilarejos da Amazônia, tem se alastrado e chegado às grandes cidades do país, alertou pesquisador da USP durante palestra na 69ª Reunião Anual da SBPC, em Belo Horizonte -
Pesquisa revela como o exercício físico protege o coração
19 de julho de 2017Por meio de experimentos com ratos e células, grupo do ICB-USP mostrou que treinamento físico aeróbico reativa um sistema que ajuda a livrar as células cardíacas de mitocôndrias disfuncionais -
Dezoito novos livros da Editora Unesp podem ser baixados gratuitamente
18 de julho de 2017E-books abrangem as áreas de Artes, Ciência da Informação, Ciências da Motricidade, Ciências Sociais, Comunicação, Educação, entre outros -
Missão de Startups Brasil – Argentina 2017
18 de julho de 2017Serão selecionadas até 15 empresas que terão oportunidade de inserção no mercado argentino; prazo de inscrição encerra em 31 de julho -
FAPESP, FAPs e Medical Research Council lançam chamada na área de saúde
18 de julho de 2017Propostas devem ser realizadas por pesquisadores de instituições brasileiras e britânicas com foco na melhoria do sistema de saúde e das condições de saúde de populações vulneráveis -
Nobel de Química 2016 defende foco de pesquisa em ciência básica
18 de julho de 2017Sir James Fraser Stoddart, um dos desenvolvedores das máquinas moleculares, esteve no Brasil para participar da IUPAC 2017 -
Pesquisadores da USP investigam o potencial de uso dos resíduos agroindustriais
17 de julho de 2017Projeto, focado no emprego de materiais não tóxicos e na produção sustentável, já resultou na criação de placas de fibrocimento e em painéis de aglomerados de biomassa para múltiplas finalidades -
ICMC contrata dois professores temporários para a área de estatística
17 de julho de 2017Contratos terão duração de seis meses, podendo ser prorrogados. Prazo de inscrição termina em 21 de julho -
FAPESP e Finep lançam nova chamada do PIPE/PAPPE Subvenção
17 de julho de 2017Programa apoia o desenvolvimento por empresas paulistas de produtos, processos e serviços inovadores -
Prêmio Josué de Castro de combate à fome abre inscrições
14 de julho de 2017Iniciativa do Consea/SP premiará a formulação de soluções concretas para o combate à fome e a promoção de segurança alimentar e nutricional -
Instituto de Oceanografia da USP abre vaga para professor doutor
14 de julho de 2017O cargo será em Regime de Dedicação Integral à Docência e à Pesquisa (RDIDP), com salário de R$ 10.670,76. Inscrição até 1º de agosto -
IUPAC ratifica, no Brasil, quatro novos elementos químicos
14 de julho de 2017Para presidente da União Internacional de Química Pura e Aplicada, decisão de confirmar os elementos Nihonium (Nh), Moscovium (Mc), Tennessine (Ts) e Oganesson (Og) foi uma homenagem à Sociedade Brasileira de Química -
Estudo abre caminho para novo tratamento contra perda óssea
14 de julho de 2017Grupo da USP de Ribeirão Preto comprovou que o aumento nos níveis da proteína quemerina, observado em pacientes com doenças relacionadas à inflamação crônica, pode causar prejuízos ao tecido ósseo -
Químico holandês desenvolve técnicas para entender a comunicação das bactérias
13 de julho de 2017Denominado pela revista Nature como “o cartógrafo químico”, Peter Dorrestein tem criado novos métodos para identificar moléculas produzidas por micróbios durante suas interações metabólicas -
Casa da Ciência abre inscrições para novos pesquisadores
13 de julho de 2017O programa prevê o desenvolvimento de um projeto de iniciação científica, envolvendo pesquisadores da USP de Ribeirão Preto e alunos da rede básica de ensino -
Prazos de submissão de cinco chamadas da FAPESP encerram em julho
13 de julho de 2017Editais foram lançados em parceria com o CSIC, da Espanha, e Statoil Brasil Óleo e Gás e incluem também o programa SPRINT, o apoio à modernização de institutos de pesquisa e o PIPE -
O Instituto Serrapilheira lança sua 1ª chamada pública com foco em jovens cientistas
12 de julho de 2017Inicialmente serão selecionados 70 projetos com seed grants de até R$ 100 mil. Após um ano, de 10 a 20 projetos receberão aportes de até R$ 1 milhão para mais três anos de pesquisa -
Novos estudos reformulam modelos sobre as estrelas supernovas
12 de julho de 2017Entrevista com José Groh, professor de astrofísica no Trinity College Dublin, da Irlanda -
Mamífero saltava há mais de 140 milhões de anos
12 de julho de 2017Estudos com pegadas fossilizadas indica que locomoção por meio de saltos, comum entre os cangurus atuais, também estava presente na era Mesozoica no Brasil -
Morre Ecléa Bosi, professora emérita do Instituto de Psicologia da USP
11 de julho de 2017Idealizadora da Universidade Aberta à Terceira Idade e autora de dezenas de livros, ela tinha 80 anos -
A.C.Camargo Cancer Center abre seleção para iniciação científica
11 de julho de 2017Fundação Antônio Prudente tem 17 vagas entre as linhas de pesquisa básica e clínica. Inscrições até 19 de julho -
Escola São Paulo de Ciência Avançada aborda mudanças climáticas de forma integrada
11 de julho de 2017Programação do evento, que reúne estudantes de pós-graduação e jovens pesquisadores de 35 países, inter-relaciona bases científicas, adaptação, vulnerabilidade e mitigação -
Fungo inalado com a poeira causa grave doença em trabalhadores rurais
11 de julho de 2017O diagnóstico laboratorial e sorológico e a distribuição epidemiológica da enfermidade são objetos de estudo realizado na Universidade Federal de São Paulo -
Apoio à pesquisa em SP será destaque da FAPESP na Reunião Anual da SBPC
10 de julho de 2017Panorama da produção científica paulista será mostrado em Belo Horizonte, durante 69ª Reunião Anual da Sociedade Brasileira para o Progresso da Ciência (SBPC), de 16 a 22 de julho -
Pesquisador do Inpe recebe prêmio internacional na área de clima espacial
10 de julho de 2017Walter Gonzalez foi o autor do primeiro modelo sobre a interação do vento solar com a magnetosfera terrestre, área de estudo fundamental para a segurança dos satélites que orbitam a Terra e dos equipamentos eletrônicos -
Estudo de conchas mostrou como o oceano reagiu ao aquecimento do planeta
10 de julho de 2017Pesquisa realizada pelo IG-USP pode contribuir para o aprimoramento de modelos climáticos que buscam definir cenários futuros -
IEA recebe inscrições para a 3ª Intercontinental Academia
07 de julho de 2017Os encontros ocorrerão em março de 2018 em Cingapura e em março de 2019 em Birmingham, no Reino Unido -
Unicamp abrirá inscrição para Pós em Arquitetura, Tecnologia e Cidade
07 de julho de 2017Programa oferece, no máximo, 80 vagas; inscrições iniciam em 1º de agosto -
Cientista vira empreendedora e cria empresa de nanoengenharia
07 de julho de 2017Bióloga celular brasileira Margaret Magdesian montou startup no Canadá que produz dispositivos do tipo organ-on-a-chip para aumentar a eficiência dos ensaios com culturas de células -
Estudo explica por que pacientes com herpes-zóster sentem dor
07 de julho de 2017Em artigo publicado no The Journal of Neuroscience, pesquisadores da USP mostram papel da citocina TNF no surgimento da neuralgia herpética. Descoberta abre caminho para novas abordagens terapêuticas -
USP oferece o curso “Astronomia para Docência – Sistema Solar”
06 de julho de 2017Programa voltado para professores do Ensino Fundamental I visa contribuir para a melhoria do ensino de Astronomia. Inscrição até 10 de julho -
ICMC anuncia resultado do Prêmio Gutierrez de Teses de Doutorado
06 de julho de 2017Melhor tese de doutorado em matemática defendida em 2016 receberá premiação em cerimônia que ocorrerá no dia 28 de agosto, quando também será entregue uma menção honrosa -
CTC/PUC-Rio seleciona professor para o Departamento de Engenharia Mecânica
06 de julho de 2017Vaga é oferecida para candidatos com Doutorado ou doutorandos com defesa de tese até setembro. Inscrições se encerram dia 31 de julho -
Controle da paisagem
06 de julho de 2017Softwares ajudam a monitorar a saúde das árvores das cidades -
Pesquisa possibilita controlar a contaminação de castanhas-do-pará por micotoxinas
06 de julho de 2017Estudo realizado por pesquisadores do Ital também contribuiu para estabelecer regulamentos nacionais e internacionais sobre limites máximos tolerados de substâncias tóxicas produzidas por fungos no fruto da castanheira -
TECNIOspring, da Catalunha, abre chamada para intercâmbio de pesquisadores
05 de julho de 2017Programa oferece bolsa para interessados em realizar pesquisa aplicada em instituições ou empresas locais pelo período de dois anos -
São Paulo sediará Congresso Mundial de Química
05 de julho de 2017Encontro reunirá três Prêmios Nobel e destacados pesquisadores de 43 países entre os dias 9 e 14 de julho -
Projeto de produção de energia a partir de efluentes vence etapa nacional do G-BIB
05 de julho de 2017Startup de professores e estudantes da Universidade de Taubaté vai representar o Brasil em competição de inovação em bioeconomia, em outubro -
Pesquisadores brasileiros incorporam flutuações quânticas ao conceito da entropia
05 de julho de 2017Estudo teórico, publicado na Physical Review Letters, poderá ter futuras aplicações em nanodispositivos e computação, criptografia e comunicação quânticas -
Laboratório da Poli-USP ingressa em rede internacional em parceria com a Finlândia
04 de julho de 2017Faculdade é a primeira do Brasil a entrar na Design Factory Global Network, rede com foco em ensino de inovação e empreendedorismo -
CDMF participa de projeto de restauração de materiais paleontológicos
04 de julho de 2017Nanomateriais são aplicados sobre pequenos fragmentos de marfim procedente das presas de um mamute encontrado em Barcelona, na Espanha -
Programa FAPESP de Pesquisa sobre Mudanças Climáticas Globais tem nova chamada
04 de julho de 2017Serão apoiados projetos em temas relacionados à mitigação e adaptação às mudanças climáticas -
Estudo de células do sistema nervoso pode ajudar a desvendar doenças degenerativas
04 de julho de 2017Pesquisa mostra que a micróglia humana tem muitos genes com expressão diferente da micróglia de camundongos, usada em estudos de doenças como Alzheimer. Trabalho foi publicado na Nature Neuroscience -
Data de realização do Unicamp de Portas Abertas é alterada
03 de julho de 2017Unicamp transfere início da UPA do segundo para o primeiro semestre. A alteração começa a valer a partir de 2018 -
Nova reserva ecológica na USP tem vegetação nativa da Mata Atlântica
03 de julho de 2017Reserva situada na Cidade Universitária tem extensão de 10 hectares e expande ainda mais as áreas verdes preservadas pela universidade -
Molécula aumenta taxa de prenhez e número de crias em bovinos
03 de julho de 2017Descoberta desenvolvida por pesquisadores de startup apoiada pelo Programa PIPE em parceria com a USP, resultou em produto voltado a aumentar a eficiência reprodutiva animal -
Em busca do diagnóstico precoce para ELA
03 de julho de 2017Pesquisadores tentam identificar marcadores genéticos para a esclerose lateral amiotrófica e verificam importância de se analisar mais cuidadosamente a medula espinhal nos casos da doença -
FAPESP comemora 20 anos do PIPE, programa de apoio à pesquisa inovativa em empresas
30 de junho de 2017Programa apoiou ao longo dessas duas décadas 1.788 projetos de pesquisa, de 1.100 pequenas empresas de base tecnológica situadas em 127 cidades no Estado de São Paulo -
CEM disponibiliza base de dados sobre mobilidade por bicicletas em SP
30 de junho de 2017Banco conta com informações georreferenciadas sobre cada ciclovia, estações de bicicletas compartilhadas e bicicletários
Mais lidas do mês
-
Fungo patogênico transmitido pelo arranhão do gato doméstico está presente em animais selvagens
19 de junho de 2026
-
Cientistas propõem medidas para conter avanço de fungos resistentes a medicamentos
23 de junho de 2026
-
Homens idosos que dormem mais de nove horas têm maior risco de perder mobilidade
22 de junho de 2026
-
Corpo aproveita pouco os minerais das castanhas, diz estudo que simulou a digestão humana
11 de junho de 2026
-
São Paulo terá a primeira usina do país para capturar e armazenar carbono do etanol de cana
11 de junho de 2026
-
Relógio inteligente detecta ansiedade e estresse em tempo real
08 de junho de 2026
-
O cientista brasileiro que liderou a digitalização de 400 anos de história da flora do planeta
16 de junho de 2026
-
Atividade física ao longo da vida reduz risco de depressão na velhice
24 de junho de 2026
-
Pesquisadoras descobrem nova espécie de microrganismo adaptado a frio e calor extremos na Antártida
01 de junho de 2026
-
Estudo detalha como o organismo se adapta a dietas com muita proteína e nenhum carboidrato
15 de junho de 2026